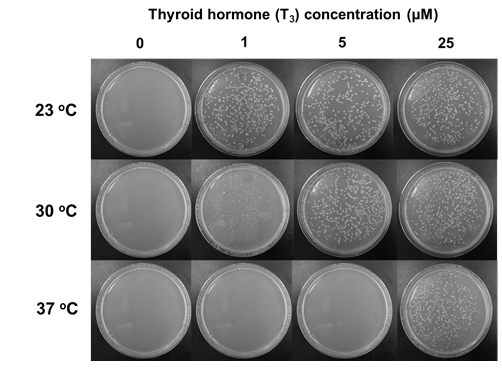

Αναζήτηση
ΚΛΕΙΣΙΜΟΕνζυμική και Συνθετική Βιοτεχνολογία
Δρ. Γιώργος Σκρέτας
Our activities lie at the interface of chemistry, biology and engineering. Enzyme & Synthetic Biotechnology (ESB) is a multi-disciplinary group employing researchers with different types of expertise, such as molecular biology, engineering, chemistry and agricultural sciences.

The main goal of ESB is the development of engineered microbial cells with the ability to perform novel and complex functions by employing principles of Synthetic Biology. The lab utilizes simple organisms, such as the bacterium Escherichia coli and the yeast Saccharomyces cerevisiae as “biological chassis” and seeks to evolve them into efficient cell factories for the production of valuable chemical and biological products, and for the performance of industrially important processes, such as drug sensing and discovery, biotransformations etc. Genetic engineering techniques are applied in order to redesign and rearrange the genome of the organism of interest, while protein engineering (directed protein evolution) and synthetic biology approaches are utilized so as to introduce novel functions in the cell. A key aspect of the work that is carried out is the design and development of high-throughput screening systems, which are used to isolate the rare biomolecules and microbial strains that execute the desired function among large combinatorial libraries comprising hundreds of millions of variants.

Dr. Georgios Skretas, was awarded a Consolidator Grant from the European Research Council (ERC) to develop engineered bacteria that accelerate drug discovery against diseases caused by protein misfolding.
Research activities
It has been widely recognized that many incurable diseases with an enormous socioeconomic impact, such as Alzheimer’s disease, Parkinson’s disease, amyotrophic lateral sclerosis, type 2 diabetes etc., are initiated by a common molecular mechanism: the misfolding of specific proteins. With the ultimate goal of identifying compounds with potentially therapeutic effects against these disorders, we have developed a highly versatile synthetic biology platform for discovering macrocyclic rescuers of disease-associated protein misfolding. In this system, large combinatorial libraries of cyclic oligopeptides (>200 million members) are biosynthesized in Escherichia coli cells and simultaneously screened for their ability to rescue disease-associated protein misfolding using an ultrahigh-throughput genetic screen. Hit compounds identified by this screen, are subjected to more detailed evaluation by biochemical and biophysical methods of protein analysis, and their ability to inhibit protein misfolding-induced pathogenicity is evaluated using appropriate mammalian cell assays and in vivo models of the disease of interest. Medicinal chemistry approaches are subsequently employed to optimize the biological properties of the bioactive macrocycles in order to generate therapeutic leads against the target diseases.

We are currently targeting the following proteins involved in misfolding diseases:
Amyloid-β peptide & Alzheimer’s disease

Cu/Zn superoxide dismutase (SOD1) & Amyotrophic lateral sclerosis (ALS)

p53 & Cancer

Polyglutaminated (polyQ) huntingtin & Huntington’s disease
α-Synuclein & Parkinson’s disease
Immunoglobulin light chains & Light chain amyloidosis
β2-Microglobulin (β2m) & Dialysis-related amyloidosis
Rhodopsin & Retinitis pigmentosa
- We have identified hundreds of head-to-tail cyclic oligopeptide sequences that inhibit the misfolding and aggregation of Αβ. For four of them, termed ΑβC5-34, ΑβC5-116, ΑβC7-1 and ΑβC7-14 we have shown that they interfere with the normal course of Aβ aggregation and the formation of typical Aβ fibrils, generating species with reduced binding to the neuronal surface and reduced cytotoxicity in vitro and in vivo (Matis, I. et al., Nature Biomedical Engineering, 2017; Delivoria, D.C. et al., Sciences Advances, 2019).
- We have identified hundreds of head-to-tail cyclic oligopeptide sequences that inhibit the misfolding and aggregation of mutant human SOD1, associated with familial forms of ALS. For one of them, termed SOD1C5-4, we have shown that it interferes with the normal course of mutant SOD1 aggregation and the formation of typical mutant SOD1 aggregates in vitro. We have found that SOD1C5-4 is cell-permeable and that it reduces the formation and cytotoxicity of mutant SOD1 aggregates in human cell lines (Matis, I. et al., Nature Biomedical Engineering, 2017).
Membrane proteins (MPs) perform critical cellular functions in all living organisms and constitute major targets for drug discovery. Escherichia coli has been the most popular overexpression host for membrane protein biochemical/structural studies. Bacterial production of recombinant membrane proteins, however, is typically hampered by poor cellular accumulation and severe toxicity for the host, which leads to low final biomass and minute volumetric yields. We have recently demonstrated that it is possible to rewire the E. coli protein-producing machinery so that it can withstand the toxicity caused by membrane protein overexpression, and that engineered bacterial strains with the ability to achieve high-level MP production can be generated. To achieve this, we searched for bacterial genes whose co-expression can suppress membrane protein-induced toxicity and identified two highly potent effectors: the membrane-bound DnaK co-chaperone DjlA, and the inhibitor of the mRNA-degrading activity of the E. coli RNase E RraA. We have generated two new E. coli strains co-expressing either djlA or rraA, which we have named SuptoxD and SuptoxR, respectively, and we have shown that these new strains accumulate markedly higher levels of final biomass and produce dramatically enhanced yields for a variety of prokaryotic and eukaryotic recombinant membrane proteins. In most cases that we have tested so far, either SuptoxD, or SuptoxR, or both, outperform the capabilities of commercial strains frequently utilized for recombinant membrane protein production purposes, such as C41(DE3), C43(DE3) and Lemo21(DE3).

- We have developed the first set of engineered bacterial strains, termed E. coli SuptoxD and SuptoxR, with a general ability to suppress the cytotoxicity caused by the overexpression of recombinant membrane proteins (Gialama et al., ACS Synthetic Biology, 2017).
- Either SuptoxD, or SuptoxR, or both, have been found to outperform the capabilities of commercial strains frequently utilized for recombinant membrane protein production purposes, such as C41(DE3), C43(DE3) and Lemo21(DE3) in the cases that we have tested (Gialama et al., ACS Synthetic Biology, 2017).
- E. coli SuptoxD and SuptoxR can produce hard-to-express recombinant membrane proteins of sufficicent quality and quantitity for biochemical and structural studies (Michou et al., ACS Synthetic Biology, 2019; Michou et al., Bioprotocol, 2020)
- We have developed second-generation E. coli SuptoxD/R strains (SuptoxD2.0 & SuptoxR2.1/2.2) achieving further enhanced levels of recombinant membrane protein production (Michou et al., Biotechnology and Bioengineering, 2020; Vasilopoulou et al., ACS Synthetic Biology, 2022, under revision).
Enzymes are biocatalysts used in a wide range of “white biotechnology” applications. Hydrolases, a specific class of enzymes, have received great attention due to their high selectivity, potential synthetic ability and broad range of applicability, especially in the production of fine chemicals and pharmaceuticals. Despite their advantages, a very limited number of hydrolases are currently being used in the industry. This is due to the fact that many industrially relevant processes require high temperatures where conventional biocatalysts perform poorly. For such processes, thermo- or hyperthermostable enzymes are required. Thermophilic organisms are a potential rich source of such enzymes, which, however, remains largely unexplored. To address this, we apply systematic genomic and metagenomic screening approaches to identify novel hydrolases from microorganisms residing in extreme environments around the globe.

- We have discovered and characterized biochemically and structurally a new thermostable and highly halotolerant GH5 cellulase (CelDZ1) and have used them to perform industrially relevant biotransformations (Giannakopoulou et al., Catalysts, 2019)
- We have discovered a thermostable esterolytic enzyme (EstDZ2) that defines a new family of bacterial esterases (Family XV) (Zarafeta et al., Scientific Reports, 2016; Myrtollari et al., Bioorganic Chemistry, 2020)
- We have discovered and characterized biochemically and structurally one of the most thermostable esterolytic enzymes described to date (EstDZ3) (Zarafeta et al., Frontiers in Microbiology, 2016; Papanikolaou et al., in submission, 2022; Charavgi et al., in preparation)
- We have discovered and characterized biochemically a new thermostable xylanase (XynDZ5)
- We have created protein-based molecular switches for controllable activation of arbitrary protein targets in living cells (Skretas, G., and Wood, D.W., Protein Science, 2005)
- We have generated the first bacterial biosensors with the ability to detect the presence of human hormones (Skretas, G., and Wood, D.W., Journal of Molecular Biology, 2005)
- Our engineered biosensors can discriminate between the action of hormone agonists and antagonists (Skretas, G.* et al., Journal of the American Chemical Society, 2007)
- We have used one of our engineered biosensors to perform chemical library screening for the discovery of new selective estrogen receptor modulators (Skretas, G.* et al., Journal of the American Chemical Society, 2007)
Television interviews
- Interview on the ΕRΤ channel TV documentary “The roads to economic growth”:
https://webtv.ert.gr/ert2/16ion2019-oi-dromoi-tis-anaptyxis/?fbclid=IwAR3KlUkUf2uuJ5dF5vcQAlZKfa-IpI9edEbD8nWTGByxAzIexlFSTnp2oIw - Interview on the ΕRΤ3 channel TV show i-lab:
https://webtv.ert.gr/ert3/i-lab/22dek2018-i-lab/
Newspaper interviews
- Interview in “Kathimerini”:
https://www.kathimerini.gr/1032541/article/epikairothta/ellada/ekanan-thn-idea-toys-epixeirhsh - Interview in “Naftemporiki”:
https://www.naftemporiki.gr/story/1423235/xrimatodotisi-ellina-ereuniti-gia-baktiria-sotires - Interview in “Kathimerini”: http://www.kathimerini.gr/1000909/article/epikairothta/ellada/ena-kyttariko-ergasthrio-kata-as8eneiwn
- Interview in “Avgi”:
http://www.avgi.gr/article/10965/8644050/tropopoiemena-bakteria-boethoun-sten-anakalypse-neon-pharmakon-kata-neuroekphylistikon-astheneion
Press releases
Engineered bacteria for the discovery of chemical rescuers of disease-associated protein misfolding
- http://health.in.gr/news/scienceprogress/article/?aid=1500171023
- http://www.skaipatras.gr/2017/11/02/ellines-epistimones-aneptyxan-tropopiimena-vaktiria-gia-tin-anakalypsi-neon-farmakon-gia-tis-nevroekfylistikes-pathisis/
- http://www.avgi.gr/article/10965/8488436/ellenes-epistemones-aneptyxan-tropopoiemena-bakteria-pou-boethoun-sten-anakalypse-neon-pharmakon
- http://pub.lucidpress.com/275828af-a166-49a6-af23-63d5a226315a/?src=em
- http://www.cretalive.gr/health/ellhnes-ereynhtes-allazoyn-ta-dedomena-stis-neyroekfylistikes-pathhseis
- https://news.makedonias.gr/2017/10/3204885/
- http://www.haniotika-nea.gr/ellines-erevnites-allazoun-ta-dedomena-stis-nevroekfilistikes-pathisis/
- http://www.iatropedia.gr/ygeia/elliniko-alma-stin-therapeia-ton-nevroekfylistikon-pathiseon-ti-petychan-epistimones-tou-e-e/91406/
- http://www.nooz.gr/world/tropopoiimena-vaktiria-gia-neuroekfulistikes-pa8iseis
- http://www.patrisnews.com/ellines-epistimones-aneptyxan-tropopiimena-vaktiria-gia-tin-anakalypsi-neon-farmakon-gia-tis-nevroekfylistikes-pathisis/
- http://www.multi-news.gr/in-ellines-erevnites-allazoun-dedomena-stis-nevroekfilistikes-pathisis/
- http://www.nooz.gr/science/tropopoiimena-vaktiria-gia-neuroekfulistikes-pa8iseis
- http://healthmag.gr/post/8944/allazoyn-ta-dedomena-stis-neyroekfylistikes-pathhseis-ti-brhkan-ellhnes-ereynhtes
- http://blog.nowdoctor.gr/28374-epistimones-aneptuxan-tropopoiimena-baktiria-pou-boithoun-stin-anakalupsi-neon-farmakon-gia-tis-neuroekfulistikes-pathiseis/
- https://nucleus.gr/?p=7070
- http://www.amna.gr/health/article/200149/Epistimones-tou-Ethnikou-Idrumatos-Ereunon-aneptuxan-tropopoiimena-baktiria-pou-boithoun-stin-anakalupsi-neon-farmakon-gia-tis-neuroekfulistikes-pathiseis
- https://analitis.gr/episthmones-toy-ethnikoy-idrymatos-ereynwn-aneptyksan-tropopoihmena-bakthria-poy-bohthoyn-sthn-anakalypsh-newn-farmakwn-gia-tis-neyroekfylistikes-pathhseis/
- https://emvolos.gr/nea-farmaka-gia-tis-nevroekfylistikes-pathisis-apo-ellines-epistimones-tou-ethnikou-idrymatos-erevnon/
- http://www.typosthes.gr/gr/igia-epistimi/article/143154/ellines-epistimones-enadia-stis-neuroekfulistikes-pathiseis–ti-anakalupsan/
Engineering bacteria to detect the presence of human hormones and anti-hormones
- http://www.sciencedaily.com/releases/2007/07/070718163719.htm
- http://www.princeton.edu/engineering/news/publications/equad-news/s07/articles/foh.xml?id=559
- http://it.moldova.org/news/engineered-e-coli-may-lead-to-new-drugs-59688-eng.html
- http://news.webindia123.com/news/ar_showdetails.asp?id=707200081&cat=&n_date=20070720
Competitive research grants
![]() |
2019-2024. European Research Council (ERC) Consolidator Grant. Project title: “A unified drug discovery platform for protein misfolding diseases”. Total budget: 1,972,000 €. Lab budget: 1,972,000 €. Coordinator-Principal Investigator: Dr. Georgios Skretas. |
![]() |
2021-2024. Hellenic Foundation for Research and Innovation. Scholarships to PhD candidates. Doctoral research fellow: Eftychia Karyda. Total budget: 28,800 €. Lab budget: 28,800 €. Coordinator-Principal Investigator: Dr. Georgios Skretas. |
![]() |
2021-2023. National Strategic Reference Framework 2014-2020. General Secretariat of Research and Technology – Research program “Research-Create-Innovate”. Project title: “Systematic development and commercial exploitation of novel aggregation inhibitors of the protein α-synuclein”. Total budget: 1,000,000 €. Lab budget: 157,000 €. Coordinator-Principal Investigator: Dr. Georgios Skretas. |
![]() |
2021-2023. National Strategic Reference Framework 2014-2020. General Secretariat of Research and Technology – Research program “Research-Create-Innovate”. Project title: “Cost-effective CO2 Capture and Utilization from magnesite/lime industry using enzyme-boosted K2CO3 Solvents”. Total budget: 1,000,000 €. Lab budget: 210,000 €. Principal Investigator for NHRF: Dr. Georgios Skretas. |
| 2021-2023. Empirikion Foundation. Research program “Support for scientific studies”. Project title: “Application of synthetic biology approaches for discovering rescuers of pathogenic protein misfolding”. Total budget: 10,000 €. Lab budget: 10,000 €. Coordinator-Principal Investigator: Dr. Georgios Skretas. | |
![]() |
2020-2023. National Strategic Reference Framework 2014-2020. General Secretariat of Research and Technology – Research program “Research-Create-Innovate”. Project title: “Development of new functional fish-superfoods for more efficient fish farming”. Total budget: 1,000,000 €. Lab budget: 183,000 €. Principal Investigator for NHRF: Dr. Georgios Skretas. |
![]() |
2020-2021. National Strategic Reference Framework 2014-2020. General Secretariat of Research and Technology – Research program “Research support with an emphasis on young researchers”. Project title: “Development of second-generation specialized bacterial strains for high-level recombinant membrane protein production”. Total budget: 37,000 €. Lab budget: 37,000 €. Coordinator-Principal Investigator: Dr. Georgios Skretas. |
![]() |
2019-2022. National Strategic Reference Framework 2014-2020. General Secretariat of Research and Technology – Special Actions “Aquaculture – Industrial Materials – Open Innovation in Culture”. Project title: “Development of new functional fish-superfoods for more efficient fish farming”. Total budget: 200,000 €. Lab budget: 60,000 €. Role: Principal Investigator. Declined |
![]() |
2020-2022. National Strategic Reference Framework 2014-2020. Fellowships for Post-doctoral Research. Post-graduate research fellow: Dr. Dimitra Zarafeta. Total budget: 26,000 €. Lab budget: 26,000 €. Coordinator-Principal Investigator: Dr. Georgios Skretas. |
![]() |
2020-2022. National Strategic Reference Framework 2014-2020. Fellowships for Post-doctoral Research. Post-graduate research fellow: Dr. Dafni Delivoria. Total budget: 26,000 €. Lab budget: 26,000 €. Coordinator-Principal Investigator: Dr. Georgios Skretas. |
![]() |
2020-2022. National Strategic Reference Framework 2014-2020. Fellowships for Post-doctoral Research. Post-graduate research fellow: Dr. Anastasia Galanopoulou. Total budget: 26,000 €. Lab budget: 26,000 €. Coordinator-Principal Investigator: Dr. Georgios Skretas. |
![]() |
2020-2022. National Strategic Reference Framework 2014-2020. Fellowships for Post-doctoral Research. Post-graduate research fellow: Dr. Maria Tsekrekou. Total budget: 26,000 €. Lab budget: 26,000 €. Coordinator-Principal Investigator: Dr. Georgios Skretas. |
![]() |
2019-2022. Hellenic Foundation for Research and Innovation. Scholarships to PhD candidates. Doctoral research fellow: Eleni Vasilopoulou. Total budget: 32,400 €. Lab budget: 32,400 €. Coordinator-Principal Investigator: Dr. Georgios Skretas. |
![]() |
2018-2021. Horizon 2020. Call: H2020-NMBP-TR-IND-2018-2020 (TRANSFORMING EUROPEAN INDUSTRY). Topic: BIOTEC-01-2018. Project title: “Fostering Synthetic Biology standardisation through international collaboration” (BioRoboost). Total budget: 2,000,000 €. Lab budget: 10,200 €. Principal Investigator for NHRF: Dr. Georgios Skretas. |
![]() |
2018-2021. Hellenic Foundation for Research and Innovation. Research Projects for Postdoctoral Researchers. Project title: “Targeting secretion and misfolding of α-synuclein to reduce transmission of pathology in Parkinson’s disease: An interdisciplinary approach coupling neurobiology with biotechnology”. Coordinator: Dr. Evangelia Emmanouilidou. Total budget: 180,000 €. Lab budget: 36,000 €. Principal Investigator for NHRF: Dr. Georgios Skretas. |
![]() |
2018-2021. National Strategic Reference Framework 2014-2020. Fellowships for Doctoral Research IKY-NSRF. Doctoral research fellow: Maria Giannakou. Total budget: 29,400 €. Lab budget: 29,400 €. Coordinator-Principal Investigator: Dr. Georgios Skretas. |
![]() |
2018-2020. National Strategic Reference Framework 2014-2020. General Secretariat of Research and Technology – Research program “Support of infrastructures for research and Innovation”. Project title: “Synthetic Biology: from omics technologies to genomic engineering (OMIC-ENGINE)”. Coordinator: Prof. Kostas Mathiopoulos. Total budget: 4,000,000 €. Lab budget: 70,000 €. Principal Investigator for NHRF: Dr. Georgios Skretas. |
![]() |
2017-2020. National Strategic Reference Framework 2014-2020. General Secretariat of Research and Technology – Research program “KRIPIS”. Project title: “Targeted therapeutic approaches against degenerative conditions_B”. Coordinator: Dr. Alexandros Pintzas. Total budget: 900,000 €. Lab budget: 24,000 €. |
![]() |
2018-2019. National Strategic Reference Framework 2014-2020. General Secretariat of Research and Technology – Research program “Research support with an emphasis on young researchers”. Project title: “Novel biocatalytic devices for effective exploitation of plant biomass”. Coordinator: Prof. Ηaralambos Stamatis. Total budget: 56,350 €. Lab budget: 15,000 €. Principal Investigator for NHRF: Dr. Georgios Skretas. |
![]() |
2017-2019. National Strategic Reference Framework 2014-2020. Fellowships for Post-doctoral Research. Post-graduate research fellow: Dr. Artemis Giannakopoulou. Total budget: 26,000 €. Lab budget: 26,000 €. Coordinator-Principal Investigator: Dr. Georgios Skretas. Declined by the Fellow. |
![]() |
2016-2019. National Strategic Reference Framework 2014-2020. Fellowships for Doctoral Research. Doctoral research fellow: Myrsini Michou. Total budget: 29,400 €. Lab budget: 29,400 €. Coordinator-Principal Investigator: Dr. Georgios Skretas. |
![]() |
2016-2017. State Scholarships Foundation (IKY) Fellowships of Excellence in Postgraduate Studies – Siemens Program. Post-graduate research fellow: Dr. Zacharoula Linardaki. Total budget: 24,000 €. Lab budget: 24,000 €. Coordinator-Principal Investigator: Dr. Georgios Skretas. |
![]() |
2016-2017. State Scholarships Foundation (IKY) Fellowships of Excellence in Postgraduate Studies – Siemens Program. Post-graduate research fellow: Dr. Artemis Giannakopoulou. Total budget: 17,000 €. Lab budget: 17,000 €. Coordinator-Principal Investigator: Dr. Georgios Skretas. Declined by the Fellow. |
![]() |
2015-2017. Research Program “Excellence” State Scholarships Foundation (IKY) – Siemens. Project title: “Thermostable enzymic nanodevices as catalysts for the production of biofuels from renewable carbon sources”. Coordinator: Prof. Dimitris Hatzinikolaou. Total budget: 50,000 €. Lab budget: 24,800 €. Principal Investigator for NHRF: Dr. Georgios Skretas. |
![]() |
2015-2017. State Scholarships Foundation (IKY) Fellowships of Excellence in Postgraduate Studies – Siemens Program. Post-graduate research fellow: Dr. Stamatia Bellou. Total budget: 37,000 €. Lab budget: 37,000 €. Coordinator-Principal Investigator: Dr. Georgios Skretas. |
![]() |
2015. John S. Latsis Public Benefit Foundation – Scientific Studies. Project title: “Protein tools for programming cell behavior in synthetic biology”. Total budget: 12,000 €. Lab budget: 12,000 €. Coordinator-Principal Investigator: Dr. Georgios Skretas. |
![]() |
2013-2015. State Scholarships Foundation (IKY) Fellowships of Excellence in Postgraduate Studies – Siemens Program. Post-graduate research fellow: Dr. Kalliopi Kostelidou. Total budget: 40,000 €. Lab budget: 40,000 €. Coordinator-Principal Investigator: Dr. Georgios Skretas. |
![]() |
2013-2015. National Strategic Reference Framework 2007-2013. General Secretariat of Research and Technology – Research program “KRIPIS”. Project title: “Targeted therapeutic approaches against degenerative conditions”. Coordinator: Dr. Alexandros Pintzas. Total budget: 1,500,000 €. Lab budget: 48,000 €. |
![]() |
2013. John S. Latsis Public Benefit Foundation – Scientific Studies. Project title: “Using bacteria and worms for the battle against Alzheimer’s disease”. Coordinator: Dr. Niki Chondrogianni. Total budget: 12,000 €. Lab budget: 6,000 €. Role: co-Coordinator. |
![]() |
2012-2015. National Strategic Reference Framework 2007-2013. General Secretariat of Research and Technology – Research program “ARISTEIA”. Project title: “Directed Evolution of Small-Molecule Therapeutics Against Neurodegenerative Diseases”. Total budget: 216,000 €. Lab budget: 190,000 €. Coordinator-Principal Investigator: Dr. Georgios Skretas. |
![]() |
2012-2015. National Strategic Reference Framework 2007-2013. Greek Ministry of Education, Research and Religious Affairs – Research program “THALIS”. Project title: “Biosynthesis and Genetic Selection of Cyclic Peptides with Potential Therapeutic Effects Against Alzheimer’s Disease: Inhibitors of Aβ aggregation”. Coordinator: Dr. Stathis Gonos. Total budget: 540,000 €. Lab budget: 171,000 €. Principal Investigator for NHRF: Dr. Georgios Skretas. |
![]() |
2011-2015. FP7 European Union Cooperation Program KBBE-2010.3.5-04 – Microbial diversity and metagenomic mining for biotechnological innovation. Project title: “Systematic screening for novel hydrolases from hot environments”. Coordinator: Prof. Xu Peng. Total budget: 5,500,000 €. Lab budget: 150,000 €. |
![]() |
2011-2015. FP7 European Union Marie-Curie International Reintegration Grant. Project title: “Directed evolution of small-molecule cancer therapeutics”. Coordinator: Dr. Sotiris Kyrtopoulos. Total budget: € 100,000. Lab budget: € 100,000. Marie Curie Fellow: Dr. Georgios Skretas. |
![]() |
2011-2015. National Strategic Reference Framework 2007-2013. General Secretariat of Research and Technology – Research program “SYNERGASIA”. Project title: “Development of novel Angiogenesis-Modulating Pharmaceuticals by screening of natural compounds and synthetic analogues”. Coordinator: Prof. Nektarios Aligiannis Total budget: 1,412,000 €. Lab budget: € 150,000. |
*Denotes corresponding author
- Vasilopoulou, Ε., Giannakopoulou, A., Kapsalis, H., Michou, M., Michoglou-Sergiou, A., Kolisis, F.N., Skretas, G.* 2022. Second-generation Escherichia coli SuptoxR strains for further enhanced production of recombinant membrane proteins in bacteria. ACS Synthetic Biology. Accepted after revisions
- Skretas, G.* and Ventura, S.* 2020. Editorial: Protein Aggregation and Solubility in Microorganisms (Archaea, Bacteria and Unicellular Eukaryotes): Implications and Applications. Frontiers in Microbiology. 11:620239.
- Myrtollari, K., Katsoulakis, N., Zarafeta, D., Pavlidis, I., Skretas, G., Smonou, I.* 2020. Activity and specificity studies of the new thermostable esterase EstDZ2. Bioorganic Chemistry. 104:104214.
- Michou, M., Delivoria, D.C., Skretas, G.* 2020. High-level production of recombinant membrane proteins using the engineered Escherichia coli Strains SuptoxD and SuptoxR. Bio-protocol. 10(15).
- Michou, M., Stergios, A., Skretas, G.* 2020. SuptoxD2.0: A second-generation Escherichia coli strain achieving further enhanced recombinant membrane protein production. Biotechnology and Bioengineering. 117(8):2434-2445.
- Zarafeta, D., Galanopoulou, A., Kaili, S., Chegkazi, M.S., Chrysina, E.D., Kolisis, F.N., Hatzinikolaou, D.G.*, Skretas, G.* 2020. XynDZ5: A new thermostable GH10 xylanase. Frontiers in Microbiology. 11:545.
- Giannakopoulou, A., Patila, M., Spyrou, K., Chalmpes, N., Zarafeta, D., Skretas, G., Gournis, D., Stamatis, H.* 2019. Development of a Four-Enzyme Magnetic Nanobiocatalyst for Multi-Step Cascade Reactions. Catalysts. 9: 995.
- Delivoria, D. C., Chia S., Habchi, J., Perni, M., Matis, I., Papaevgeniou, N., Chondrogianni, N., Dobson, C. M., Vendruscolo, M., Skretas, G.* 2019. Bacterial production and direct functional screening of expanded molecular libraries for discovering inhibitors of protein aggregation. Science Advances. 5 : eaax5108.
- Michou, M., Kapsalis, C., Pliotas, C., Skretas, G.* 2019. Optimization of recombinant membrane protein overexpression in the engineered Escherichia coli strains SuptoxD and SuptoxR. ACS Synthetic Biology. 8(7):1631-1641.
- Ladoukakis, Ε., Koutsandreas, Τ., Pilalis, Ε., Zarafeta, D., Kolisis, F.N., Skretas, G., Chatziioannou, A.* 2019. ANASTASIA: a distributed pipeline for automated integration, analysis and functional characterization of next-generation sequencing metagenomic datasets. Frontiers in Genetics. 10: 469.
- Wohlgemuth, R.*, Littlechild, J., Monti, D., Schnorr, K., Siebers, B., Menzel, P., van Rossum, T., Kublanov, I., Rike, A.G., Skretas, G., Szabo, Z., Peng, X., Young, M. 2018. Discovery of Novel Hydrolases from Hot Environments. Biotechnology Advances. 36(8): 2077-2100.
- Kostelidou, K., Matis, M., and Skretas, G*. 2018. Microbial genetic screens and selections for monitoring protein misfolding: tools for the identification of disease-relevant genes and the discovery of potential therapeutic compounds against neurodegenerative diseases. Current Pharmaceutical Design. 24(19):2055-2075.
- Matis, I., Delivoria, D.C., Mavroidi, B., Papaevgeniou, N., Panoutsou, S., Bellou, S., Papavasileiou, K.D., Linardaki, Z., Stavropoulou, A.V., Vekrellis, K., Boukos, N., Kolisis, F.N., Gonos, E.S., Margarity, M., Papadopoulos, M.G., Efthimiopoulos, S., Pelecanou, M., Chondrogianni, N., Skretas, G*. 2017. An integrated bacterial system for the discovery of chemical rescuers of disease-associated protein misfolding. Nature Biomedical Engineering. 1, 838–852.
- News & Views commentary in Nature Biomedical Engineering:
https://www.nature.com/articles/s41551-017-0149-y - Interview in the newspaper “Avgi” regarding this work:
http://www.avgi.gr/article/10965/8644050/tropopoiemena-bakteria-boethoun-sten-anakalypse-neon-pharmakon-kata-neuroekphylistikon-astheneion - Press releases regarding this work:
http://health.in.gr/news/scienceprogress/article/?aid=1500171023
http://www.skaipatras.gr/2017/11/02/ellines-epistimones-aneptyxan-tropopiimena-vaktiria-gia-tin-anakalypsi-neon-farmakon-gia-tis-nevroekfylistikes-pathisis/
http://www.avgi.gr/article/10965/8488436/ellenes-epistemones-aneptyxan-tropopoiemena-bakteria-pou-boethoun-sten-anakalypse-neon-pharmakon
http://pub.lucidpress.com/275828af-a166-49a6-af23-63d5a226315a/?src=em
http://www.cretalive.gr/health/ellhnes-ereynhtes-allazoyn-ta-dedomena-stis-neyroekfylistikes-pathhseis
https://news.makedonias.gr/2017/10/3204885/
http://www.haniotika-nea.gr/ellines-erevnites-allazoun-ta-dedomena-stis-nevroekfilistikes-pathisis/
http://www.iatropedia.gr/ygeia/elliniko-alma-stin-therapeia-ton-nevroekfylistikon-pathiseon-ti-petychan-epistimones-tou-e-e/91406/
http://www.nooz.gr/world/tropopoiimena-vaktiria-gia-neuroekfulistikes-pa8iseis
http://www.patrisnews.com/ellines-epistimones-aneptyxan-tropopiimena-vaktiria-gia-tin-anakalypsi-neon-farmakon-gia-tis-nevroekfylistikes-pathisis/
http://www.multi-news.gr/in-ellines-erevnites-allazoun-dedomena-stis-nevroekfilistikes-pathisis/
http://healthmag.gr/post/8944/allazoyn-ta-dedomena-stis-neyroekfylistikes-pathhseis-ti-brhkan-ellhnes-ereynhtes
http://blog.nowdoctor.gr/28374-epistimones-aneptuxan-tropopoiimena-baktiria-pou-boithoun-stin-anakalupsi-neon-farmakon-gia-tis-neuroekfulistikes-pathiseis/
https://nucleus.gr/?p=7070
http://www.amna.gr/health/article/200149/Epistimones-tou-Ethnikou-Idrumatos-Ereunon-aneptuxan-tropopoiimena-baktiria-pou-boithoun-stin-anakalupsi-neon-farmakon-gia-tis-neuroekfulistikes-pathiseis
https://analitis.gr/episthmones-toy-ethnikoy-idrymatos-ereynwn-aneptyksan-tropopoihmena-bakthria-poy-bohthoyn-sthn-anakalypsh-newn-farmakwn-gia-tis-neyroekfylistikes-pathhseis/
https://emvolos.gr/nea-farmaka-gia-tis-nevroekfylistikes-pathisis-apo-ellines-epistimones-tou-ethnikou-idrymatos-erevnon/
http://www.typosthes.gr/gr/igia-epistimi/article/143154/ellines-epistimones-enadia-stis-neuroekfulistikes-pathiseis–ti-anakalupsan/
- News & Views commentary in Nature Biomedical Engineering:
- Gialama, D., Delivoria, D.C., Michou, M., Giannakopoulou, A., Skretas, G*. 2017. Functional requirements for DjlA- and RraA-mediated enhancement of recombinant membrane protein production in the engineered E. coli strains SuptoxD and SuptoxR. Journal of Molecular Biology. 429(12):1800-1816.
- Gialama, D., Kostelidou, K., Michou, M., Delivoria, D.C., Kolisis, F.N., Skretas, G*. 2017. Development of Escherichia coli strains that withstand membrane protein-induced toxicity and achieve high-level recombinant membrane protein production. ACS Synthetic Biology. 6(2): 284-300.
- Zarafeta, D., Moschidi, D., Ladoukakis, E., Gavrilov, S., Chrysina, E.D., Chatziioannou, A., Kublanov, I., Skretas, G.*, Kolisis, F. N.*. 2016. Metagenomic mining for thermostable esterolytic enzymes uncovers a new family of bacterial esterases. Scientific Reports. 6: 38886.
- Zarafeta, D., Szabo, Z., Moschidi, D., Phan, H., Chrysina, E.D., Peng, X., Ingham, C.J., Kolisis, F. N.*, Skretas, G.*. 2016. EstDZ3: a new esterolytic enzyme exhibiting remarkable thermostability. Frontiers in Microbiology. 7:1779.
- Zarafeta, D., Kissas, D., Sayer, C., Gudbergsdottir, S. R., Ladoukakis, E., Isupov, M. N., Chatziioannou, A., Peng, X., Littlechild, J. A.*, Skretas, G.*, and Kolisis, F. N.* 2016. Discovery and characterization of a thermostable and highly halotolerant GH5 cellulase from an Icelandic hot spring isolate. PLoS One, 11(1): e0146454.
- Skretas, G.*, and Kolisis, F.N.* 2013. Combinatorial approaches for inverse metabolic engineering applications. Computational and Structural Biotechnology Journal. 3(4): e201210021.
- Skretas, G.^, Makino, T.^, Varadarajan, N., Pogson, M., and Georgiou, G. 2012. Multi-copy genes that enhance the yield of mammalian G protein-coupled receptors in Escherichia coli. Metabolic Engineering. 14(5): 591-602.
^Equal contribution - Makino, T.^, Skretas, G.^, and Georgiou, G. 2011. Strain engineering for improved expression of recombinant proteins in bacteria. Microbial Cell Factories. 10(1): 32.
^ Equal contribution
Characterized as ”Highly accessed” - Makino, T.^, Skretas, G.^, Kang, T.H., and Georgiou, G. 2011. Comprehensive engineering of Escherichia coli for enhanced expression of IgG antibodies. Metabolic Engineering. 13(2): 241-51.
^ Equal contribution - Skretas, G., and Georgiou, G. 2010. Simple genetic selection protocol for isolation of overexpressed genes that enhance accumulation of membrane-integrated human G protein-coupled receptors in Escherichia coli. Applied and Environmental Microbiology. 76(17):5852-9.
- Skretas, G., Carroll, S., DeFrees, S., Schwartz, M., Johnson, K.F., and Georgiou, G. 2009. Expression of active human sialyltransferase ST6GalNAcI in Escherichia coli. Microbial Cell Factories. 8: 50.
- Skretas, G., and Georgiou, G. 2009. Genetic analysis of G protein-coupled receptor expression in Escherichia coli: Inhibitory role of DnaJ on the membrane integration of the human central cannabinoid receptor. Biotechnology and Bioengineering. 102(2):357-367.
> “Editors’ choice” article - Skretas, G., and Georgiou, G. 2008. Engineering G protein-coupled receptor expression in bacteria. Proceedings of the National Academy of Sciences USA. 105(39):14747-14748
- Link, A.J., Skretas, G., Strauch, E.-M., Chari, N.S., and Georgiou, G. 2008. Efficient production of membrane-integrated and detergent-soluble G protein-coupled receptors in Escherichia coli. Protein Science. 17(10): 1857-63.
- Gillies, A., Skretas, G., and Wood, D.W. 2008. Engineering systems for detection and discovery of nuclear hormone-like compounds. Biotechnology Progress. 24: 8-16.
- Skretas, G.*, Meligova, A., Villalonga-Barber, C., Mitsiou, D.J., Alexis, M.N., Micha-Screttas, M., Steele, B.R., Screttas, C.G., and Wood, D.W*. 2007. Engineered chimeric enzymes as facile tools for pharmaceutical discovery: Construction of simple bacterial screens for the detection, discovery and assessment of estrogen receptor modulators. Journal of the American Chemical Society. 129: 8443-8457.
- This work has been featured in a number of press releases: http://www.sciencedaily.com/releases/2007/07/070718163719.htm
http://www.princeton.edu/engineering/news/publications/equad-news/s07/articles/foh.xml?id=559
http://it.moldova.org/news/engineered-e-coli-may-lead-to-new-drugs-59688-eng.html
http://news.webindia123.com/news/ar_showdetails.asp?id=707200081&cat=&n_date=20070720
- This work has been featured in a number of press releases: http://www.sciencedaily.com/releases/2007/07/070718163719.htm
- Skretas, G., and Wood, D.W. 2005. Rapid detection of subtype-selective nuclear hormone receptor binding with bacterial genetic selection. Applied and Environmental Microbiology. 71: 8995-8997.
- Skretas, G., and Wood, D.W. 2005. A bacterial biosensor of endocrine modulators. Journal of Molecular Biology. 349: 464-474.
Þ Selected as an Article of Outstanding Interest by “Faculty of 1000” - Skretas, G., and Wood, D.W. 2005. Regulation of protein activity with small-molecule-controlled inteins. Protein Science. 14: 523-532.
- Theologitis M., Screttas G.C., Raptis S.G. and Papadopoulos, M.G. 1999. The polarizability and hyperpolarizability of tetrakis(phenylethynyl)ethene and several of its lithiated derivatives. International Journal of Quantum Chemistry. 72: 177-187.
- Delivoria, D.C. and Skretas, G.* 2022. Advancing the discovery of chemical rescuers of pathogenic protein misfolding and aggregation by integrating SICLOPPS technology and ultrahigh-throughput screening in bacteria. Methods in Molecular Biology “Peptide Macrocycles”.
- Delivoria, D.C. and Skretas, G.* 2020. Integrated bacterial production of large combinatorial libraries of cyclic oligopeptides and functional screening for the identification of chemical rescuers of pathogenic protein misfolding and aggregation. Springer Protocols Handbook Peptide and Protein Engineering: From Concepts to Biotechnological Applications. Editors: Olga Iranzo & Ana Cecília Roque. Humana Press.
- Gialama, D., Kolisis, F.N., and Skretas, G*. 2018. New expression systems for GPCRs. In Novel Bioprocessing Technology for Production of Biopharmaceuticals and Bioproducts (Editors: W. Zhou, and C. Komives). Wiley & Sons.
- Wood, D.W., and Skretas, G. 2005. Intein reporter and selection systems. In Homing endonucleases and inteins (Editors: M. Belfort, V. Derbyshire, B.L. Stoddard, and D.W. Wood). Springer.
Technology transfer
- Wood, D.W. and Skretas, G. Bacterial ligand-binding sensor. United States Patent 7592144 (granted)
- Skretas, G. Macrocyclic rescuers for disease-associated protein misfolding. PCT/IB2018/000622 (application)
- Skretas, G. and Gialama, D. Systems for recombinant protein production. PCT/EP2017/025168 (application)
- Skretas, G. and Delivoria, D.C. Cyclic peptide inhibitors of amyloid-β aggregation. GR20190100453 (application)

Founder, CEO and CSO of ResQ Biotech (www.resqbiotech.com), an early-stage drug discovery company applying innovative biotechnologies for the discovery and pre-clinical development of putative therapeutic molecules against diseases caused by protein misfolding and aggregation, such as amyotrophic lateral sclerosis, systemic amyloidosis and cancer.
ResQ Biotech

Distinction #1
Nature has selected ResQ Biotech as a “one to watch” firm highlighted for The Spinoff Prize 2020
[https://www.nature.com/articles/d41586-020-01904-6].
For this inaugural Spinoff Prize Award, “Nature sought out the most exciting science-based companies to have emerged from academic labs in the past three years” in four sectors: Pharmaceuticals, biotechnology and medical technology; Agriculture and food technology; Chemicals and advanced materials; Digital technologies.

Distinction #2
ResQ Biotech was the winner of the MIT Enterprise Forum Greece Startup Competition 2020.
Distinction #3
ResQ Biotech has been selected by the international innovation blog VentureRadar as one of the «TOP 20 NEWLY FOUNDED UNIVERSITY SPIN-OFFS YOU SHOULD KNOW». According to VentureRadar “University spinoffs play a significant role in transferring knowledge to society, with more than 10,000 companies having been formed this way. Each year 100s more are founded, so we decided to pick out 20 of the most exciting that have been formed over the past two years. Our selection was based on filtering for companies developing products and services that address significant market problems and are well positioned to make a positive impact in the coming years. The companies span a broad range of disciplines, including drug development, medical devices, online cloud services, COVID-19 testing, indoor farming, bio-materials, battery storage, network analytics, machine vision, and trustworthy AI”.
[https://blog.ventureradar.com/2020/09/29/the-top-20-newly-founded-university-spin-offs-you-should-know/]

Distinction #4
ResQ Biotech has been selected by the editors of Startupper magazine among the 100 companies with the ability to change the business landscape of Greece characterized as «Game Changers» of the year [https://100gamechangers.gr/resq-biotech-mia-erevnitiki-spin-off-enantia-stis-pi/].
Since December 2019, ResQ Biotech has been member of the Hellenic Bio-cluster (www.hbio.gr) and since July 2021 member of the national startup registry “Elevate Greece” (www.elevategreece.gov.gr).


![]() |
2021-2023. National Strategic Reference Framework 2014-2020. General Secretariat of Research and Technology – Research program “Research-Create-Innovate”. Project title: “Preclinical development of potentially therapeutic compounds against amyotrophic lateral sclerosis (ALS)”. Total budget: 590,000 €. Company budget: 454,000 €. Coordinator-Principal Investigator: Dr. Georgios Skretas. |
![]() |
2021-2023. National Strategic Reference Framework 2014-2020. General Secretariat of Research and Technology – Research program “Research-Create-Innovate”. Project title: “Systematic development and commercial exploitation of novel aggregation inhibitors of the protein α-synuclein”. Total budget: 1,000,000 €. Company budget: 82,000 €. Coordinator-Principal Investigator: Dr. Georgios Skretas. |
![]() |
2021-2023. National Strategic Reference Framework 2014-2020. Region of Western Greece Start-up support. Project title: “Preclinical development of potentially therapeutic compounds against amyotrophic lateral sclerosis (ALS)”. Total budget: 274,000 €. Company budget: 220,000 €. Coordinator-Principal Investigator: Dr. Georgios Skretas. |








